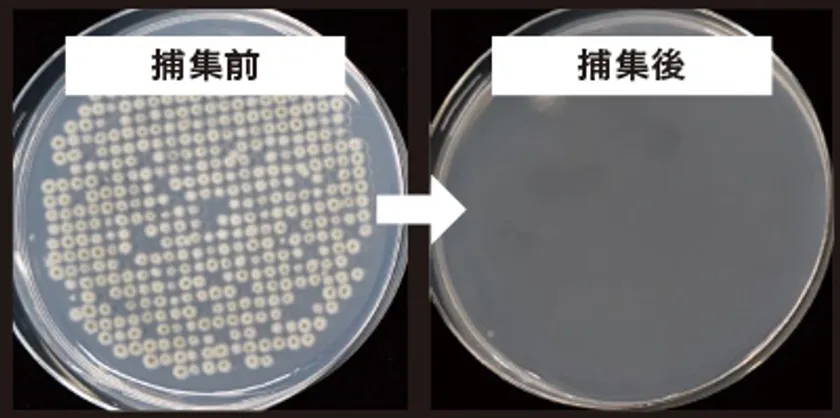

住宅用フィルタ及び業務用空気清浄機、喫煙所システムを製造・販売する株式会社トルネックス(本社:東京都中央区/代表取締役:松井 周生)は、カビの専門家である千葉大学真菌医学研究センター 矢口 貴志准教授監修の下、自社開発の電子式集塵フィルタ4種類が、浮遊カビに高い捕集効果を発揮することを確認しました。

矢口 貴志先生
検証試験を行なった通称「クロカビ」は、主に生活環境に多く繁殖しやすい身近なカビです。カビは本来土壌に生息していますが、風によって運ばれたり、人や物に付着し持ち込まれたりなどで室内に侵入します。
新型コロナウイルス対策として「窓開け換気」「加湿」が推奨されていますが、窓を開けるとカビが外の空気とともに室内に取り込まれてしまいます。さらに梅雨や夏の季節、湿った空気や暑い空気も取り込まれることで、エアコン効率が悪くなるだけではなく、カビが繁殖するのに好条件の空気環境となります。
カビが原因で起こる健康被害の一つとして、カビを吸い込むことで起こる喘息や気管支炎など呼吸器のアレルギー疾患があります。カビによる感染症は、健康な人には感染することはありませんが、免疫機能が低下すると発症しやすくなりますので、なるべくカビに接触しない空気環境を維持することが大切です。
そこで、トルネックスでは、千葉大学真菌医学研究センター 矢口 貴志准教授監修の下、トルネックス電子式集塵フィルタ4種類の浮遊カビ捕集効果を確認したところ、全ての機種においてフィルタを1回通過した時の除去率が90%以上であることを確認できました。
また、電子式集塵フィルタは、浮遊カビのほか、目に見えない様々な汚染物質(浮遊ウイルス、花粉、ホコリ、PM2.5、ダニ・カビなどのアレルゲン等)を捕集することが確認できています。今後も電子式集塵フィルタによる試験を進め、住環境をはじめとするさまざまな分野の室内空気清浄のご提案をしてまいります。
<千葉大学真菌医学研究センター 准教授 矢口 貴志(やぐち・たかし)先生のコメント>
カビは温度20~30℃、湿度60%以上で発生しやすくなり、75~90%で最も増殖しやすくなります。カビは、埃、汚れなどあらゆるもの(有機物)を栄養源にします。カビを増やさないためにはカビが好む「温度」「湿度」「栄養」「足場」を与えないことです。居住者によるこまめな掃除と併せて、空気中を浮遊するカビを除去する空気清浄機も有効です。
今回、電子式集塵フィルタにより、浮遊カビの捕集効果が確認されたことで、実生活環境においても空気中の浮遊カビ数を空気清浄により減少させる可能性があると期待されます。
2021年6月24日、オンライン配信セミナー(参加費無料)「窓開け換気で?“カビ”が家に入ってくる!『ウイルス対策』と『カビ対策』のポイントは空気にあり」を開催いたします。千葉大学真菌医学研究センター准教授 矢口貴志先生にご講演いただきます。ぜひご参加ください。
※1 定格風量時の当社内試験での結果です。
◆浮遊真菌の除去性能評価試験監修:
千葉大学真菌医学研究センター 准教授 博士(工学) 矢口 貴志先生 ご紹介
早稲田大学理工学部応用化学科卒業。明治製菓株式会社を経て、現在、千葉大学真菌医学研究センター准教授に就任。生活環境のカビ、特に病原性のカビを専門に研究。「世界一受けたい授業」「林修の今でしょ講座」などテレビ出演多数。
◆浮遊真菌の除去性能評価試験概要
・試験委託機関 : 千葉大学真菌医学研究センター
・試験品 : 電子式集塵フィルタ 4種類(型式CETX2001、CETX1501、
CETX1001、CETXG121)
・試験条件 : 試験品上流側で浮遊カビを散布し、
試験品の上流側と下流側で浮遊カビ数を測定
・試験微生物(カビ): Cladosporium cladosporioides
(クラドスポリウム・クラドスポリオイデス)
◆浮遊真菌の除去性能評価試験結果
・ワンパス(フィルタ1回通過)捕集率
型式CETX2001 99.7%
・通過風量15m3/min
浮遊真菌の除去性能評価試験結果
型式CETX1501 99.6%、CETX1001 100%、CETX2001 99.7%、CETXG121 91.8%(2 m3/min)
◆電子式集塵フィルタについて
弊社の電子式集塵フィルタは、金属の極板を数ミリ間隔で積み重ねた構造で、極板に高電圧をかけて粉塵を吸着する仕組みであり、一般的なろ過式微小粒子フィルタと異なり、圧力損失が少なく目詰まりしにくい構造のため、空気の流れを妨げずに十分な風量を確保できます。また、湿度やフィルタの汚れに応じて、自動的に最適な運転を行うことで※、使い始めと変わらない集塵性能を長期間安定的に維持できます。
※ 株式会社トルネックスの特許技術
掲載されている情報(製品の価格/仕様・サービスの内容)は、発表時の情報です。予告なしに変更される事がありますので、予めご了承下さい。
◆オンライン配信セミナー概要
窓開け換気で?“カビ”が家に入ってくる!
『ウイルス対策』と『カビ対策』のポイントは空気にあり
□日時: 2021年6月24日 15:00~16:30
□場所 :インターネット環境がある場所からご参加ください(wi-fi推奨)
Web会議アプリ「ZOOMウェビナー」を使って開催します。
お申し込み後、ご招待メールを送信いたします。
□参加費:無料
□詳細とお申込みはこちら























